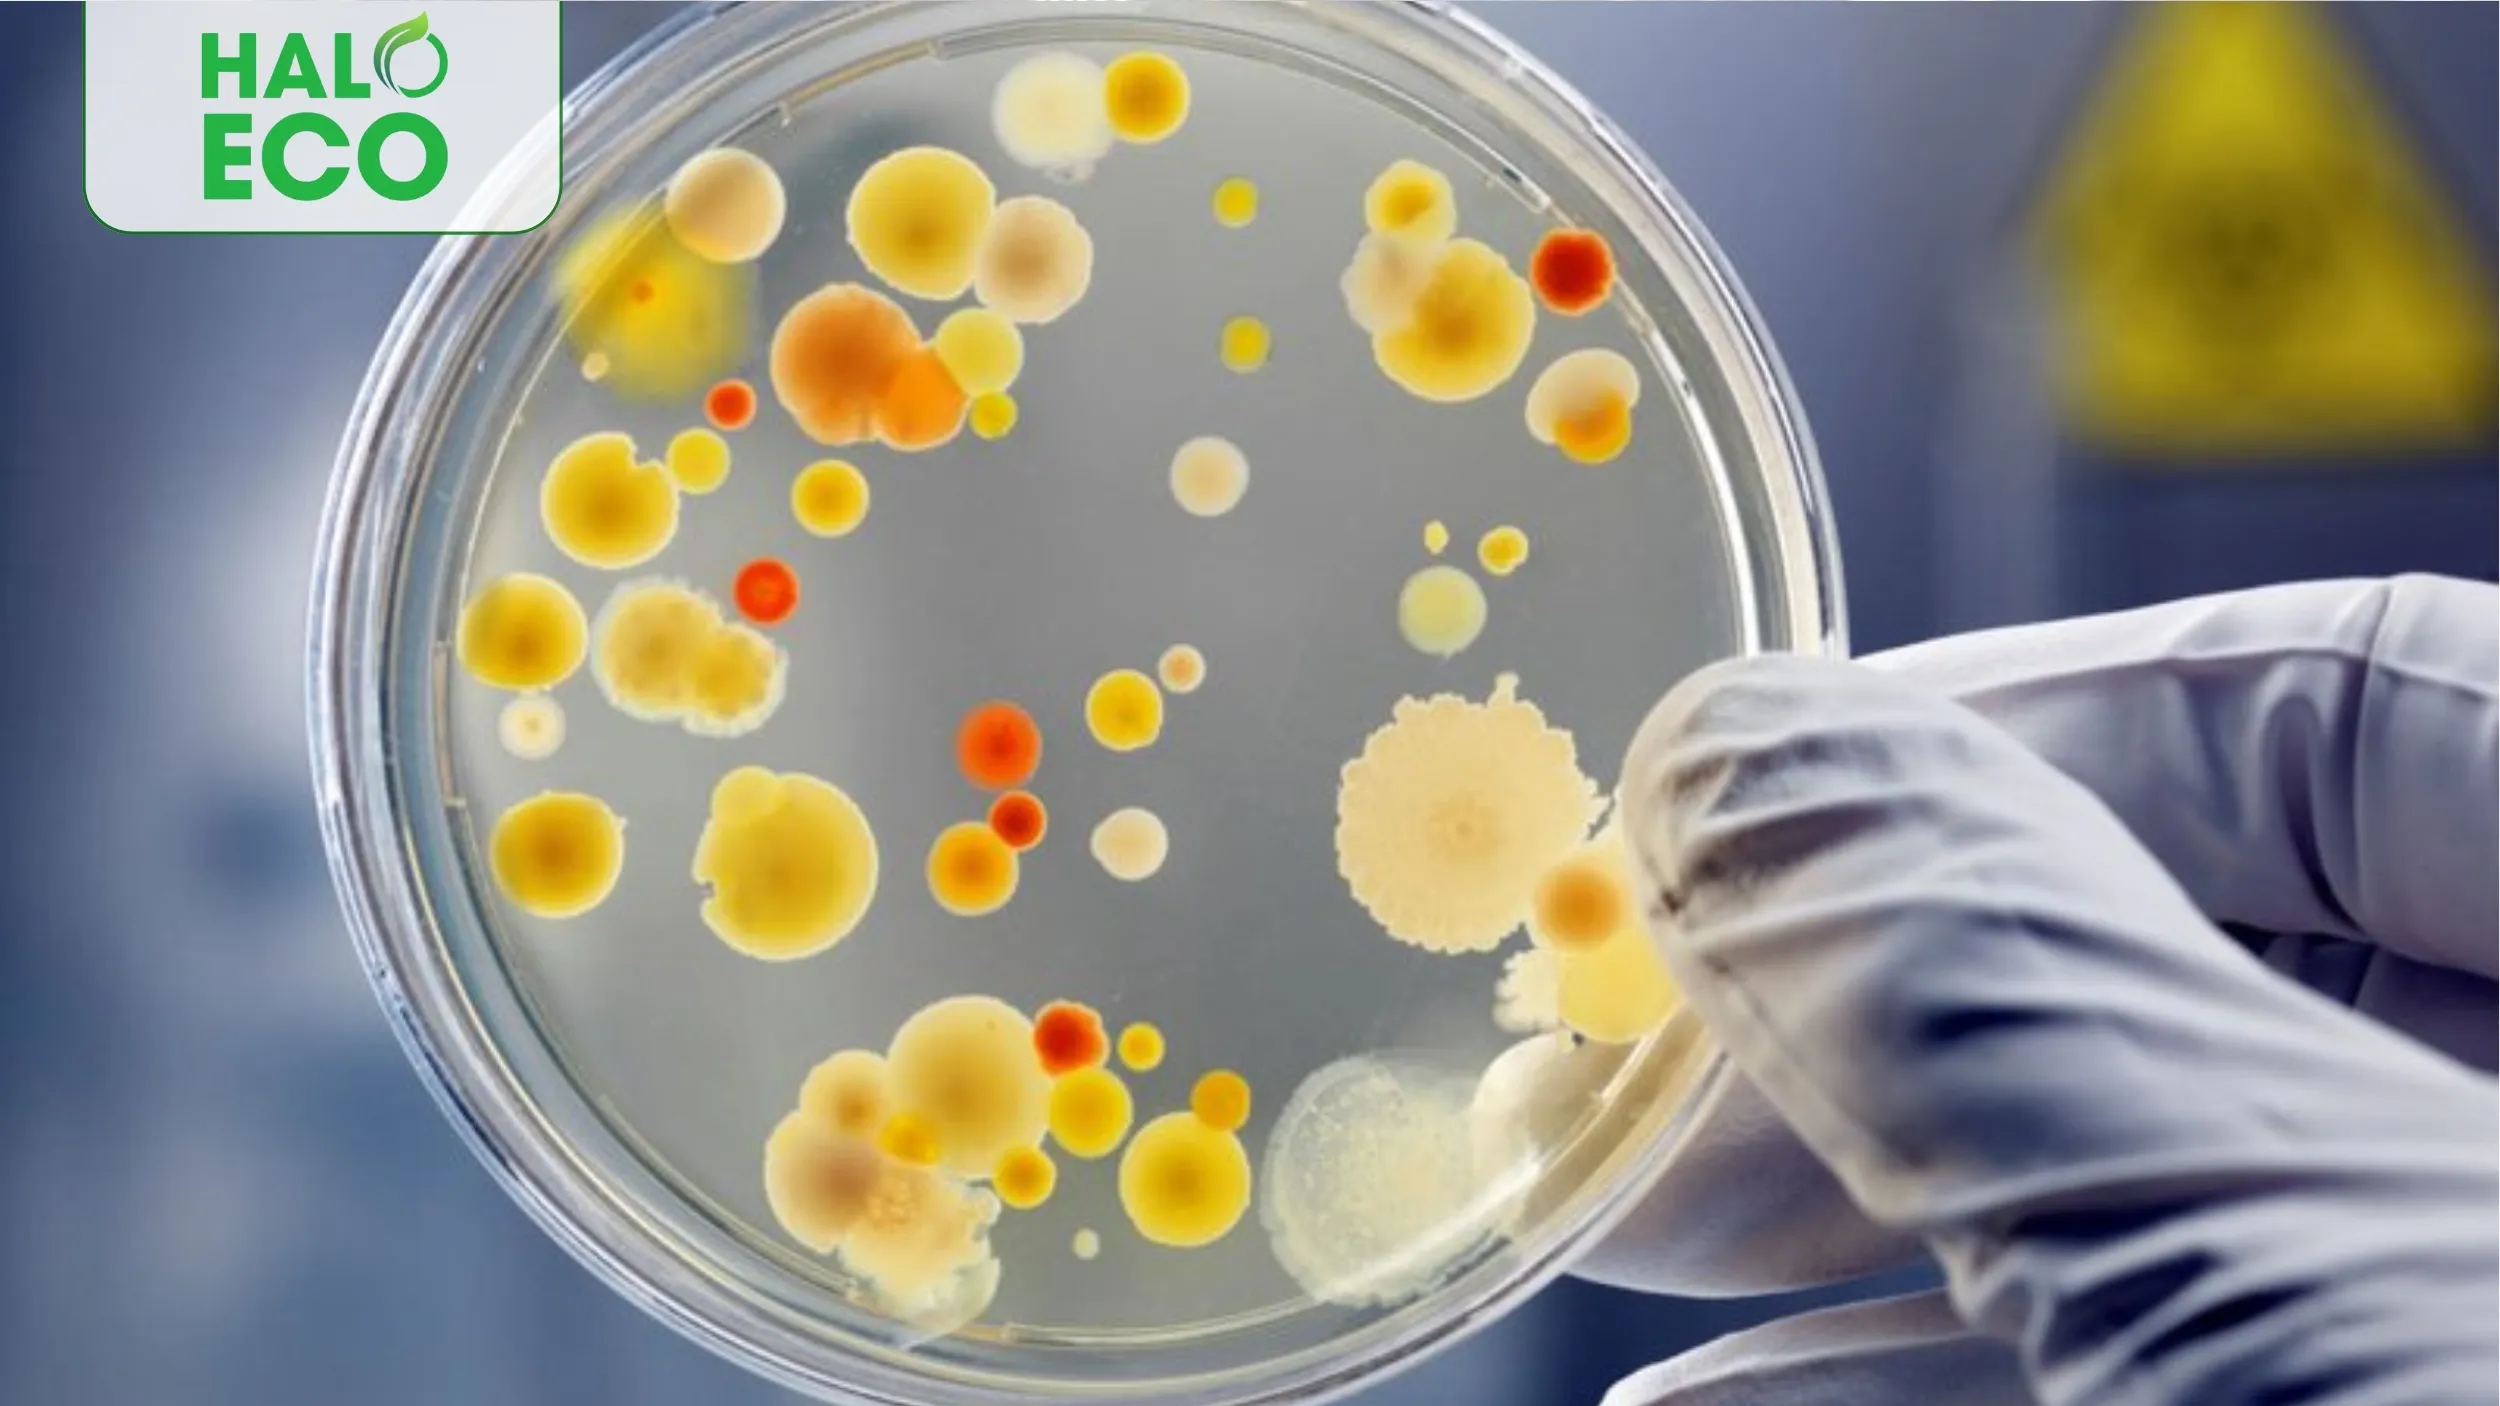

Chế phẩm sinh học là gì? Tìm hiểu giải pháp xanh giúp cải tạo đất, tăng năng suất và bảo vệ môi trường trong nông nghiệp hiện đại.

Chế phẩm sinh học đang trở thành giải pháp then chốt trong xu hướng phát triển nông nghiệp xanh, sạch và bền vững. Trước thách thức về ô nhiễm môi trường và an toàn thực phẩm, việc chuyển đổi sang các phương pháp canh tác thân thiện với môi trường trở nên cấp thiết. HalongEco tự hào là thương hiệu tiên phong cung cấp các dòng chế phẩm sinh học chất lượng cao, góp phần thúc đẩy nền nông nghiệp hữu cơ tại Việt Nam. Hãy cùng tìm hiểu về giải pháp đột phá này và những lợi ích to lớn mà nó mang lại.
1. Chế Phẩm Sinh Học Là Gì?
Chế phẩm sinh học là sản phẩm được tạo ra từ các vi sinh vật có lợi (như vi khuẩn, nấm, xạ khuẩn...) hoặc các chất được chiết xuất từ sinh vật tự nhiên. Các vi sinh vật này được phân lập, nuôi cấy và nhân sinh khối trong điều kiện kiểm soát trước khi được chế biến thành dạng bột, dạng lỏng hoặc dạng hạt để sử dụng trong nông nghiệp.
Khác với các loại phân bón và thuốc bảo vệ thực vật hóa học, chế phẩm sinh học hoạt động theo cơ chế tự nhiên, không gây hại cho môi trường, không tạo ra dư lượng độc hại và không làm phát sinh tính kháng thuốc ở dịch hại. Đây là ưu điểm vượt trội giúp chế phẩm sinh học ngày càng được ưa chuộng trong sản xuất nông nghiệp hữu cơ.
Các chế phẩm sinh học được phân loại thành nhiều nhóm khác nhau tùy theo mục đích sử dụng như: phân bón sinh học, thuốc bảo vệ thực vật sinh học, chế phẩm xử lý môi trường, chế phẩm cải tạo đất, và nhiều loại khác.
Chế Phẩm Sinh Học Là Gì?
2. Vai Trò Thiết Thực Của Chế Phẩm Sinh Học Đối Với Sản Xuất Nông Nghiệp Hiện Đại
Việc ứng dụng chế phẩm sinh học trong nông nghiệp mang lại nhiều lợi ích to lớn:
-
Cải thiện độ phì nhiêu của đất: Các vi sinh vật trong chế phẩm sinh học giúp phân hủy chất hữu cơ, cung cấp dưỡng chất và cải thiện cấu trúc đất.
-
Tăng cường sức đề kháng cho cây trồng: Nhiều loại chế phẩm sinh học có khả năng kích thích hệ thống miễn dịch của cây, giúp cây trồng tự bảo vệ trước các tác nhân gây hại.
-
Phòng trừ sâu bệnh hiệu quả: Các vi sinh vật đối kháng trong chế phẩm sinh học có thể ức chế hoặc tiêu diệt các mầm bệnh, côn trùng gây hại mà không ảnh hưởng đến hệ sinh thái.
-
Nâng cao chất lượng nông sản: Sản phẩm thu hoạch có hàm lượng dinh dưỡng cao hơn, mùi vị thơm ngon hơn và an toàn cho sức khỏe người tiêu dùng.
-
Thân thiện với môi trường: Không gây ô nhiễm đất, nước, không để lại dư lượng độc hại và bảo vệ đa dạng sinh học.
-
Tiết kiệm chi phí sản xuất: Giảm sử dụng phân bón, thuốc bảo vệ thực vật hóa học, tiết kiệm nước tưới và công lao động.
Theo thống kê, nông dân sử dụng chế phẩm sinh học có thể tiết kiệm từ 20-30% chi phí đầu tư so với canh tác truyền thống, đồng thời nâng cao giá trị sản phẩm từ 15-25% nhờ đáp ứng tiêu chuẩn hữu cơ và an toàn thực phẩm.

Vai Trò Thiết Thực Của Chế Phẩm Sinh Học Đối Với Sản Xuất Nông Nghiệp Hiện Đại.
3. Thành Phần Và Các Loại Chế Phẩm Sinh Học Phổ Biến
Thành phần của chế phẩm sinh học thường bao gồm:
Vi sinh vật có ích: Là thành phần chính, bao gồm:
- Vi khuẩn cố định đạm (Rhizobium, Azotobacter)
- Vi khuẩn phân giải phospho (Bacillus, Pseudomonas)
- Vi khuẩn đối kháng (Trichoderma, Bacillus subtilis)
- Nấm có lợi (Mycorrhiza, Trichoderma)
Chất mang: Giúp duy trì sự sống của vi sinh vật như than bùn, đất sét, bột đá vôi.
Chất dinh dưỡng: Cung cấp năng lượng cho vi sinh vật phát triển.
Chất bảo quản: Giúp duy trì độ bền và thời gian sử dụng lâu hơn cho sản phẩm.
Các loại chế phẩm sinh học phổ biến hiện nay:
-
Chế phẩm EM (Effective Microorganisms): Chứa nhiều chủng vi sinh vật có lợi, được sử dụng rộng rãi trong xử lý đất, ủ phân hữu cơ và phòng trừ bệnh hại.
-
Chế phẩm Trichoderma: Có khả năng đối kháng với nhiều loại nấm gây bệnh trên cây trồng như bệnh thối rễ, lở cổ rễ, đốm lá.
-
Chế phẩm Bacillus thuringiensis (BT): Hiệu quả trong phòng trừ sâu hại như sâu keo, sâu tơ, sâu xanh.
-
Chế phẩm nấm rễ Mycorrhiza: Giúp tăng cường khả năng hấp thu nước và dinh dưỡng cho cây, đặc biệt là phospho.
-
Chế phẩm xử lý phụ phẩm nông nghiệp: Giúp phân hủy nhanh rơm rạ, thân lá thực vật sau thu hoạch, tạo thành phân hữu cơ.
4. Cơ Chế Hoạt Động Và Ứng Dụng Thực Tế
Chế phẩm sinh học hoạt động dựa trên các cơ chế tự nhiên, phát huy tác dụng theo nhiều cách khác nhau:
Cơ chế hoạt động:
-
Cạnh tranh sinh thái: Vi sinh vật có lợi chiếm lĩnh môi trường sống, không cho mầm bệnh phát triển.
-
Ký sinh: Một số vi sinh vật trong chế phẩm có khả năng ký sinh và tiêu diệt mầm bệnh.
-
Kích thích sinh trưởng: Sản sinh hormone thực vật, enzyme và các chất kích thích tăng trưởng.
-
Phân giải chất hữu cơ: Chuyển hóa chất hữu cơ thành dạng dễ hấp thu cho cây trồng.
-
Cố định đạm: Chuyển đạm từ không khí thành dạng cây trồng có thể sử dụng.
Ứng dụng thực tế:
Ứng dụng của chế phẩm sinh học ngày càng mở rộng trong đa dạng lĩnh vực:
-
Trong trồng trọt: Xử lý đất trước khi gieo trồng, phun lên lá, tưới gốc để phòng trừ sâu bệnh và kích thích sinh trưởng.
-
Trong chăn nuôi: Bổ sung vào thức ăn và nước uống, xử lý chất thải, khử mùi chuồng trại, giảm ô nhiễm môi trường.
-
Trong thủy sản: Xử lý nước ao nuôi, cải thiện môi trường sống cho cá, tôm, giảm dịch bệnh.
-
Trong xử lý môi trường: Phân hủy chất thải hữu cơ, xử lý nước thải, khử mùi hôi.
-
Trong bảo quản nông sản: Giảm tỷ lệ hư hỏng, kéo dài thời gian bảo quản rau quả sau thu hoạch.
Kết quả nghiên cứu cho thấy, việc sử dụng chế phẩm sinh học đã giúp giảm 30-50% lượng phân bón hóa học, giảm 40-60% thuốc trừ sâu hóa học, đồng thời tăng năng suất cây trồng từ 10-30% tùy theo loại cây và điều kiện canh tác.

Cơ Chế Hoạt Động Và Ứng Dụng Thực Tế.
5. Cách Chọn Và Sử Dụng Chế Phẩm Sinh Học Hiệu Quả
Để tối ưu hóa lợi ích khi sử dụng chế phẩm sinh học trong nông nghiệp, người dùng cần chú trọng cả khâu lựa chọn sản phẩm lẫn quy trình sử dụng đúng kỹ thuật.
Tiêu chí lựa chọn chế phẩm sinh học chất lượng:
- Ưu tiên sản phẩm từ các thương hiệu uy tín như HalongEco, có nguồn gốc rõ ràng và được nhiều người tin dùng.
- Kiểm tra kỹ hạn sử dụng, điều kiện bảo quản và thông tin về mật độ vi sinh vật trên bao bì. Chọn chế phẩm có mật độ lợi khuẩn cao, chủng vi sinh vật được phân lập rõ ràng.
- Ưu tiên sản phẩm đã được kiểm định và chứng nhận chất lượng bởi các tổ chức chuyên ngành hoặc cơ quan chức năng.
- Tham khảo ý kiến từ chuyên gia hoặc người có kinh nghiệm để chọn loại chế phẩm phù hợp với mục đích sử dụng.
Hướng dẫn sử dụng chế phẩm sinh học đạt hiệu quả cao:
-
Thời điểm sử dụng: Nên dùng vào buổi sáng sớm hoặc chiều mát để vi sinh vật phát triển tốt, tránh nhiệt độ cao hoặc mưa lớn làm giảm hiệu quả.
-
Liều lượng và cách pha: Tuân thủ đúng hướng dẫn của nhà sản xuất. Pha loãng với nước sạch, không dùng nước chứa clo hoặc hóa chất sát khuẩn. Khuấy đều trước khi sử dụng để đảm bảo vi sinh vật phân bố đồng đều.
-
Kết hợp các biện pháp khác: Có thể phối hợp với phân hữu cơ hoặc các biện pháp canh tác hợp lý để tăng hiệu quả cải tạo đất và bảo vệ cây trồng. Nên luân phiên các loại chế phẩm để tránh hiện tượng cây trồng bị “lờn” hoặc giảm hiệu quả sinh học.
-
Bảo quản: Đặt chế phẩm ở nơi khô ráo, thoáng mát, tránh ánh nắng trực tiếp. Đậy kín sau khi sử dụng, không trộn lẫn với thuốc trừ sâu hay hóa chất diệt cỏ để bảo vệ hoạt tính của vi sinh vật.
Lưu ý: Chế phẩm sinh học cần thời gian để phát huy tác dụng, không cho hiệu quả tức thì như hóa chất. Người dùng cần kiên trì áp dụng đúng quy trình kỹ thuật để đạt kết quả tốt nhất.
Chế phẩm sinh học là giải pháp xanh giúp nâng cao năng suất, chất lượng nông sản và bảo vệ môi trường. Với những ưu điểm vượt trội về hiệu quả kinh tế, an toàn sinh thái và phát triển bền vững, chế phẩm sinh học đang dần thay thế các sản phẩm hóa học trong nông nghiệp.
Mọi thắc mắc và nhu cầu hợp tác về chế phẩm sinh học, xin vui lòng liên hệ thương hiệu HalongEco để được tư vấn chi tiết.
CÔNG TY CỔ PHẦN HÓA CHẤT NÔNG NGHIỆP HÀ LONG ECO
Địa chỉ nhà máy: Lô A 204, Khu công nghiệp Thái Hòa, Xã Đức Lập Hạ, Huyện Đức Hòa, Tỉnh Long An, Việt Nam.
Website: https://halongeco.com
Email: contact.haloeco@gmail.com
Hotline: 0856.555.585